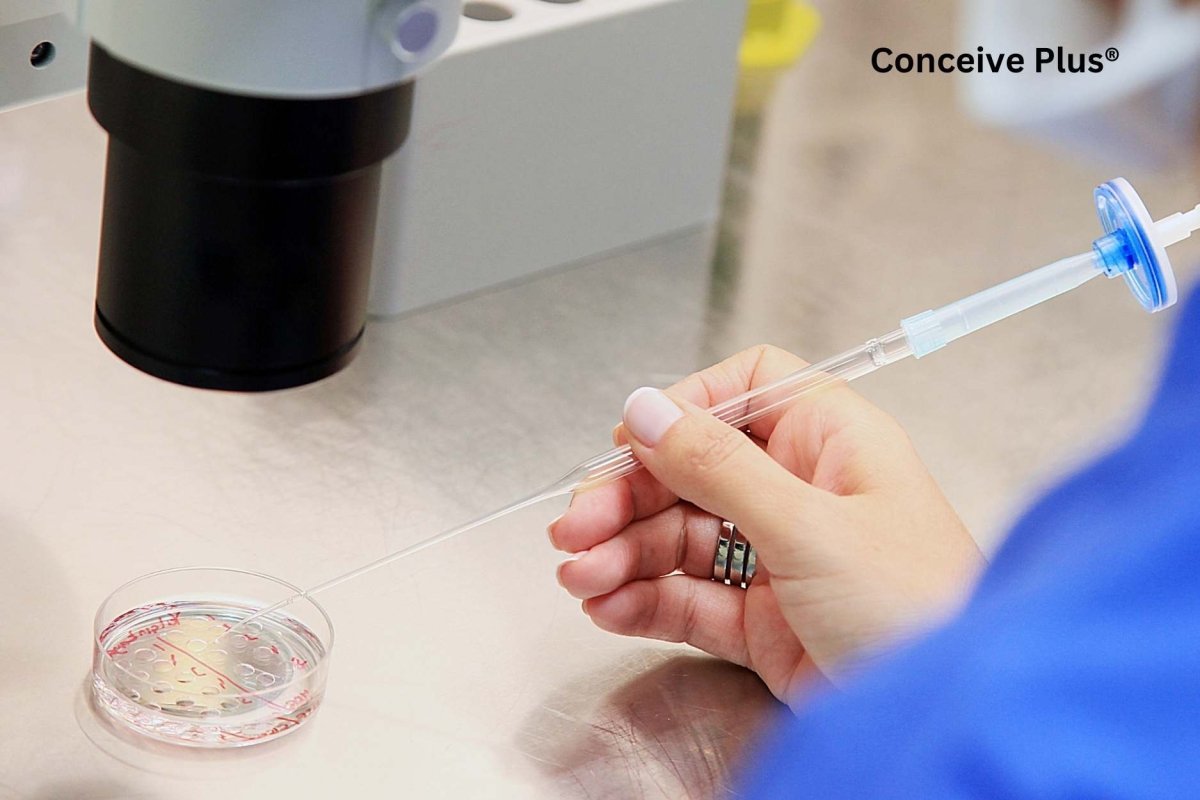
How Big Is Sperm and Fascinating Facts About Its Size and Dimensions - Conceive Plus®

Livraison express GRATUITE à partir de $60
ACHETEZ 2, ÉCONOMISEZ 7 % - ACHETEZ 3, ÉCONOMISEZ 20 %
Votre panier est vide
CONTINUER VOS ACHATS